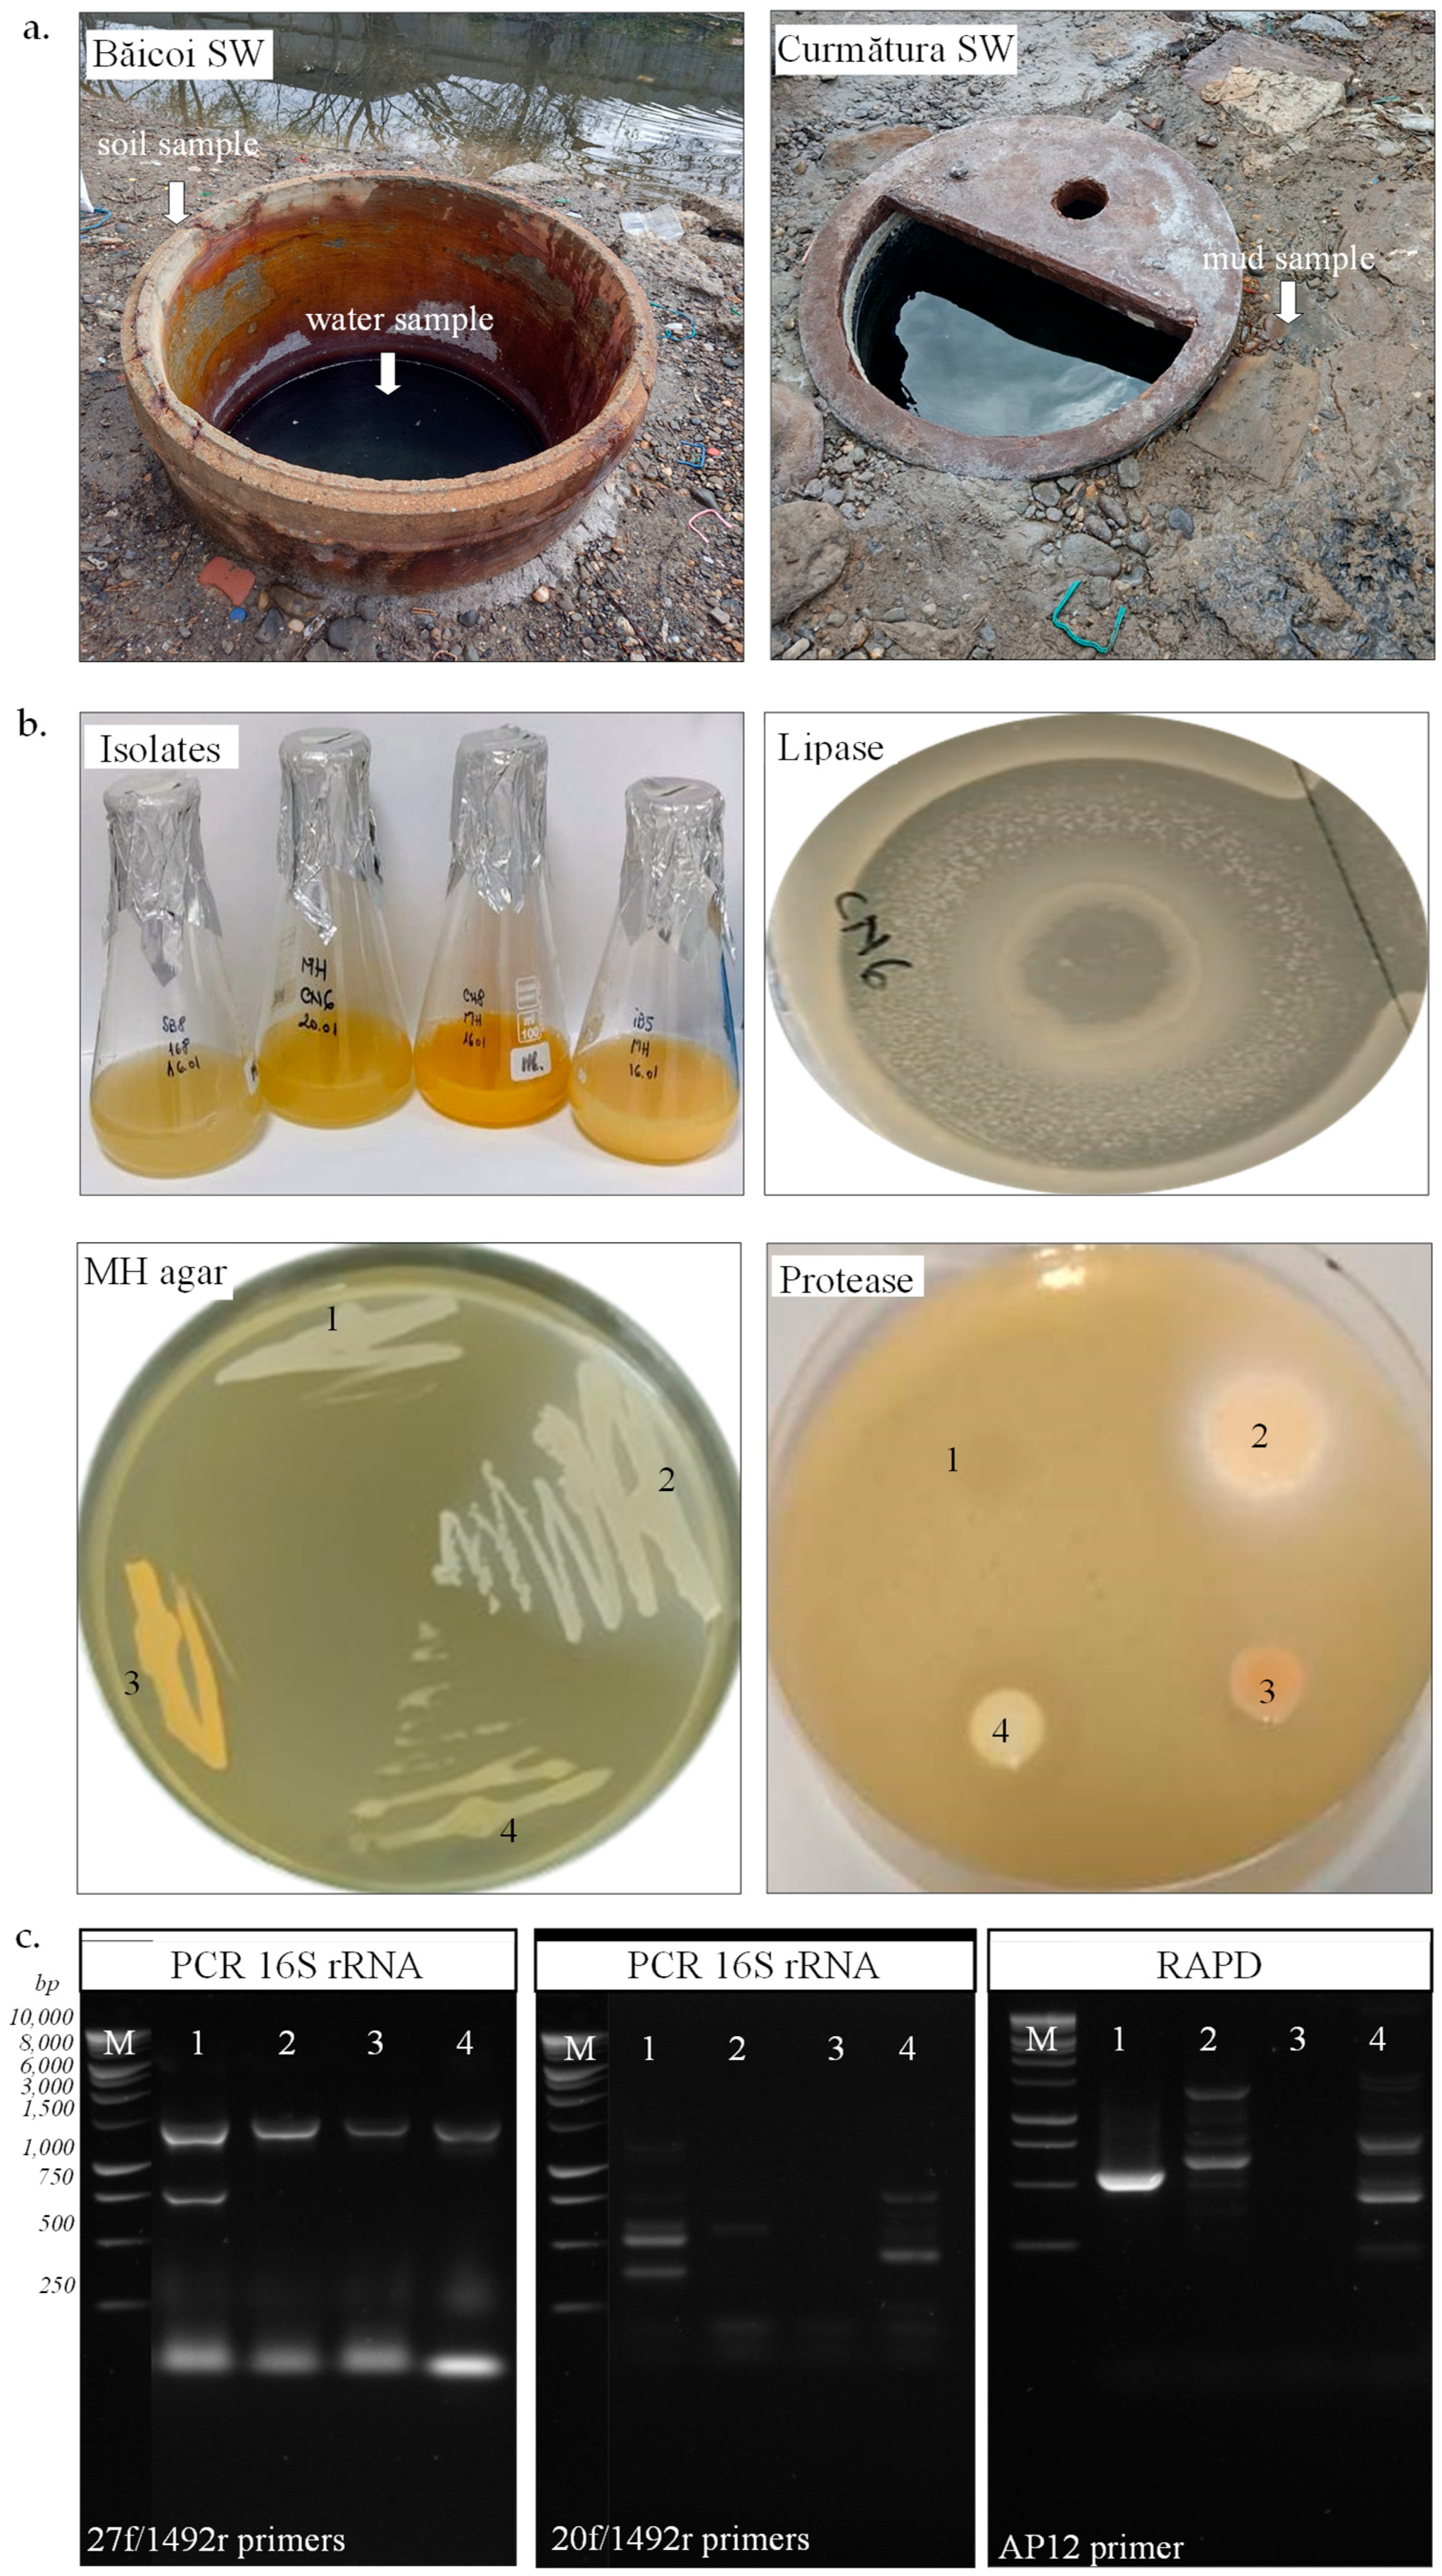
Biotech 14 00049 g001
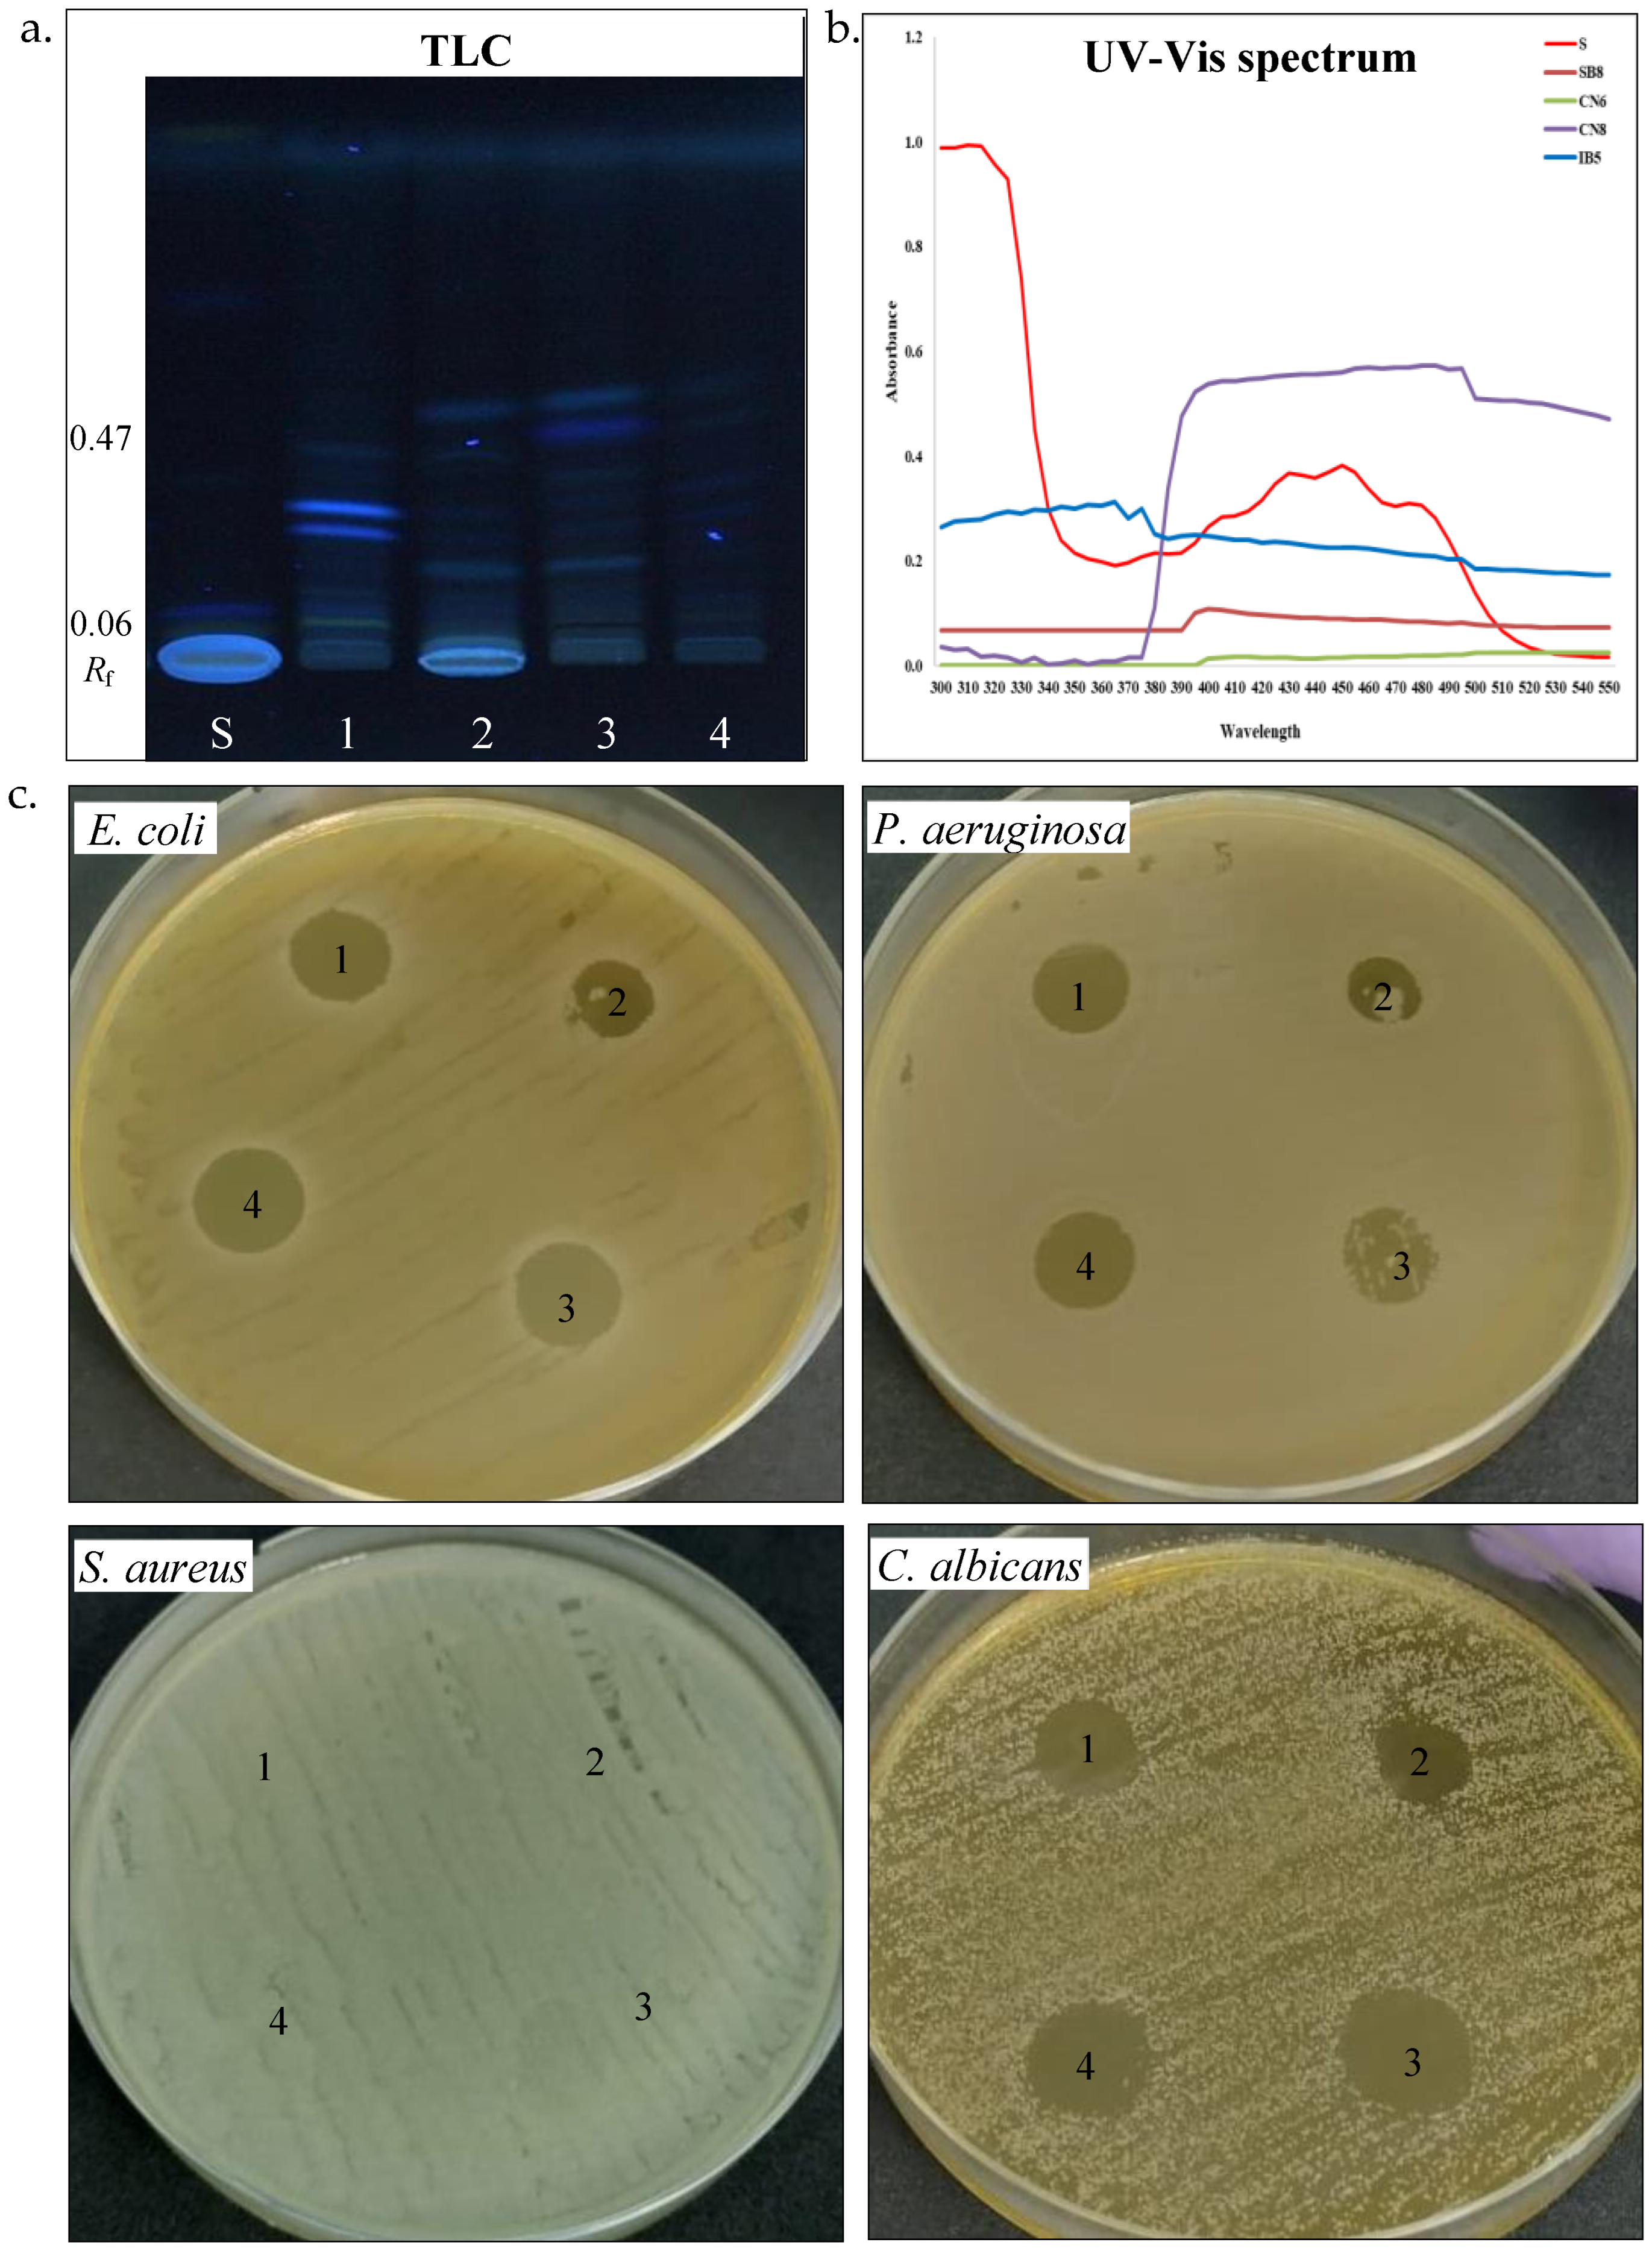
Biotech 14 00049 g005

Novel Halotolerant Bacteria from Saline Environments: Isolation and Biomolecule Production
Abstract
1. Introduction
2. Materials and Methods
2.1. Sample Collection and Physicochemical Characterization
2.2. Isolation, Characterization, and Identification of Halophiles
2.3. Biomolecule Production by Halophiles
3. Results and Discussions
3.1. Physicochemical Characteristics of Samples
3.2. Isolation, Characterization, and Identification of Halophiles
3.3. Biomolecule Production by Halophiles
4. Conclusions
Author Contributions
Funding
Institutional Review Board Statement
Informed Consent Statement
Data Availability Statement
Conflicts of Interest
References
- Gómez-Villegas, P.; Vigara, J.; León, R. Characterization of the microbial population inhabiting a solar saltern pond of the Odiel Marshlands (SW Spain). Mar. Drugs 2018, 16, 332. [Google Scholar] [CrossRef] [PubMed]
- Nosalova, L.; Piknova, M.; Bonova, K.; Pristas, P. Deep subsurface hypersaline environment as a source of novel species of halophilic sulfur-oxidizing bacteria. Microorganisms 2022, 10, 995. [Google Scholar] [CrossRef] [PubMed]
- Oren, A. Microbial life at high salt concentrations: Phylogenetic and metabolic diversity. Saline Syst. 2008, 4, 2. [Google Scholar] [CrossRef] [PubMed]
- Kanekar, P.P.; Kanekar, S.P.; Kelkar, A.S.; Dhakephalkar, P.K. Halophiles—Taxonomy, diversity, physiology and applications. In Microorganisms in Environmental Management; Satyanarayana, T., Johri, B., Prakash, A., Eds.; Springer: Dordrecht, The Netherlands, 2012. [Google Scholar]
- Dutta, B.; Bandopadhyay, R. Biotechnological potentials of halophilic microorganisms and their impact on mankind. Beni-Suef Univ. J. Basic Appl. Sci. 2022, 11, 75. [Google Scholar] [CrossRef]
- Kushner, D.J.; Kamekura, M. Physiology of halophilic Eubacteria. In Halophilic Bacteria; Rodriguez-Valera, F., Ed.; CRC Press, Inc.: Boca Raton, FL, USA, 1988; Volume I, pp. 109–138. [Google Scholar]
- Ventosa, A.; Nieto, J.J.; Oren, A. Biology of moderately halophilic aerobic bacteria. Microbiol. Mol. Biol. Rev. 1998, 62, 504–544. [Google Scholar] [CrossRef]
- Oren, A. Diversity of halophilic microorganisms: Environments, phylogeny, physiology, and applications. J. Ind. Microbiol. Biotechnol. 2002, 28, 56–63. [Google Scholar] [CrossRef]
- Galinski, E.A. Compatible solutes of halophilic Eubacteria: Molecular principles, water–solute interaction, stress protection. Experientia 1993, 49, 487–496. [Google Scholar] [CrossRef]
- Ma, Y.; Galinski, E.A.; Grant, W.D.; Oren, A.; Ventosa, A. Meeting review: Halophiles—Life in saline environments. Appl. Environ. Microbiol. 2010, 76, 6971–6981. [Google Scholar] [CrossRef]
- Poli, A.; Finore, I.; Romano, I.; Gioiello, A.; Lama, L.; Nicolaus, B. Microbial diversity in extreme marine habitats and their biomolecules. Microorganisms 2017, 5, 25. [Google Scholar] [CrossRef]
- Corral, P.; Amoozegar, M.A.; Ventosa, A. Halophiles and their biomolecules: Recent advances and future applications in biomedicine. Mar. Drugs 2019, 18, 33. [Google Scholar] [CrossRef]
- Neagu, S.; Cojoc, R.; Tudorache, M.; Gomoiu, I.; Enache, M. The lipase activity from moderately halophilic and halotolerant microorganisms involved in bioconversion of waste glycerol from biodiesel industry. Waste Biomass Valor. 2018, 9, 187–193. [Google Scholar] [CrossRef]
- Ruginescu, R.; Enache, M.; Popescu, O.; Gomoiu, I.; Cojoc, R.; Batrinescu-Moteau, C.; Maria, G.; Dumbravician, M.; Neagu, S. Characterization of Some Salt-Tolerant Bacterial Hydrolases with Potential Utility in Cultural Heritage Bio-Cleaning. Microorganisms 2022, 10, 644. [Google Scholar] [CrossRef] [PubMed]
- Benítez-Mateos, A.I.; Paradisi, F. Halomonas elongata: A microbial source of highly stable enzymes for applied biotechnology. Appl. Microbiol. Biotechnol. 2023, 107, 3183–3190. [Google Scholar] [CrossRef] [PubMed]
- Kalvandi, S.; Garousin, H.; Pourbabaee, A.A.; Farahbakhsh, M. The release of petroleum hydrocarbons from a saline-sodic soil by the new biosurfactant-producing strain of Bacillus sp. Sci. Rep. 2022, 12, 19770. [Google Scholar] [CrossRef]
- Meinzer, M.; Ahmad, N.; Nielsen, B.L. Halophilic Plant-Associated Bacteria with Plant-Growth-Promoting Potential. Microorganisms 2023, 11, 2910. [Google Scholar] [CrossRef] [PubMed]
- Upadhyaya, C.; Patel, H.; Patel, I.; Ahir, P.; Upadhyaya, T. Development of biological coating from novel halophilic exopolysaccharide exerting shelf-life-prolonging and biocontrol actions for post-harvest applications. Molecules 2024, 29, 695. [Google Scholar] [CrossRef] [PubMed]
- Subramanian, P.; Gurunathan, J. Differential production of pigments by halophilic bacteria under the effect of salt and evaluation of their antioxidant activity. Appl. Biochem. Biotechnol. 2020, 190, 391–409. [Google Scholar] [CrossRef]
- Banik, A.; Pandya, P.; Patel, B.; Rathod, C.; Dangar, M. Characterization of halotolerant, pigmented, plant growth promoting bacteria of groundnut rhizosphere and its in-vitro evaluation of plant-microbe protocooperation to withstand salinity and metal stress. Sci. Total Environ. 2018, 630, 231–242. [Google Scholar] [CrossRef]
- Kushwaha, K.; Saxena, J.; Agarwal, M.K. Identification and characterization of psychrotrophic strain of Planococcus maritimus for glucosylated C30 carotenoid production. Indian J. Exp. Biol. 2020, 58, 190–197. [Google Scholar]
- Gómez-Villegas, P.; Vigara, J.; Vila, M.; Varela, J.; Barreira, L.; Léon, R. Antioxidant, antimicrobial, and bioactive potential of two new haloarchaeal strains isolated from Odiel Salterns (Southwest Spain). Biology 2020, 9, 298. [Google Scholar] [CrossRef]
- Athmika; Ghate, S.D.; Arun, A.B.; Rao, S.S.; Arun Kumar, S.T.; Kandiyil, M.K.; Kanekar, S.; Rekha, P.D. Genome analysis of a halophilic bacterium Halomonas malpeensis YU-PRIM-29T reveals its exopolysaccharide and pigment producing capabilities. Sci. Rep. 2021, 11, 1749. [Google Scholar] [CrossRef] [PubMed]
- Jehlička, J.; Edwards, H.G.M.; Oren, A. Bacterioruberin and salinixanthin carotenoids of extremely halophilic archaea and bacteria: A Raman spectroscopic study. Spectrochim. Acta Part A Mol. Biomol. Spectrosc. 2013, 106, 99–103. [Google Scholar] [CrossRef] [PubMed]
- Giani, M.; Garbayo, I.; Vílchez, C.; Martínez-Espinosa, R.M. Haloarchaeal carotenoids: Healthy novel compounds from extreme environments. Mar. Drugs 2019, 17, 524. [Google Scholar] [CrossRef]
- Bouhamed, S.B.H.; Chaari, M.; Baati, H.; Zouari, S.; Ammar, E. Extreme halophilic archaea: Halobacterium salinarum carotenoids characterization and antioxidant properties. Heliyon 2024, 10, e36832. [Google Scholar] [CrossRef] [PubMed]
- Enache, M.; Teodosiu, G.; Faghi, A.M.; Dumitru, L. Identification of halophilic archaebacteria isolated from some Romanian salt lakes on the basis of lipids composition. Rev. Roum. Biol. Ser. Biol. Veg. 2000, 45, 93–99. [Google Scholar]
- Hauser, B.A. Chloride. In Drinking Water Chemistry: A Laboratory Manual; Hauser, B.A., Ed.; Lewis Publishers: Boca Raton, FL, USA, 2002; pp. 93–95. [Google Scholar]
- Ventosa, A.; Quesada, E.; Rodriguez-Valera, F.; Ruiz-Berraquero, F.; Ramos-Cormenzana, A. Numerical taxonomy of moderately halophilic Gram-negative rods. Microbiology 1982, 128, 1959–1968. [Google Scholar] [CrossRef]
- Rasooli, M.; Amoozegar, M.A.; Sepahy, A.A.; Babavalian, H.; Tebyanian, H. Isolation, identification and extracellular enzymatic activity of culturable extremely halophilic archaea and bacteria of IncheBoroun Wetland. Int. Lett. Nat. Sci. 2016, 56, 40–51. [Google Scholar] [CrossRef]
- Sanders, E.R. Aseptic laboratory techniques: Plating methods. J. Vis. Exp. 2012, 63, e3064. [Google Scholar]
- Holt, J.G.; Krieg, N.R.; Sneath, P.H.A.; Staley, J.T.; Williams, S.T. Bergey’s Manual of Determinative Bacteriology, 9th ed.; Williams and Wilkins: Baltimore, MD, USA, 1994. [Google Scholar]
- Marchesi, J.R.; Sato, T.; Weightman, A.J.; Martin, T.A.; Fry, J.C.; Hiom, S.J.; Wade, W.G. Design and evaluation of useful bacterium-specific PCR primers that amplify genes coding for bacterial 16S rRNA. Appl. Environ. Microbiol. 1998, 64, 795–799. [Google Scholar] [CrossRef]
- Orphan, V.J.; Hinrichs, K.U.; Ussler, W.; Paull, C.K.; Taylor, L.T.; Sylva, S.P.; Hayes, J.M.; Delong, E.F. Comparative analysis of methane-oxidizing archaea and sulfate-reducing bacteria in anoxic marine sediments. Appl. Environ. Microbiol. 2001, 67, 1922–1934. [Google Scholar] [CrossRef]
- Stancu, M.M. Kerosene tolerance in Achromobacter and Pseudomonas species. Ann. Microbiol. 2020, 70, 8. [Google Scholar] [CrossRef]
- Stancu, M.M. Characterization of new diesel-degrading bacteria isolated from freshwater sediments. Int. Microbiol. 2023, 26, 109–122. [Google Scholar] [CrossRef] [PubMed]
- Stancu, M.M. Characterization of a new Pseudomonas aeruginosa strain isolated from petroleum-polluted soil. Waste Biomass Valori. 2024, 1–13. [Google Scholar] [CrossRef]
- Stancu, M.M. Investigating the potential of native soil bacteria for diesel biodegradation. Microorganisms 2025, 13, 564. [Google Scholar] [CrossRef]
- Rohban, R.; Amoozegar, M.A.; Ventosa, A. Screening and isolation of halophilic bacteria producing extracellular hydrolyses from Howz Soltan Lake, Iran. J. Ind. Microbiol. Biotechnol. 2009, 36, 333–340. [Google Scholar] [CrossRef] [PubMed]
- Hiyama, T.; Nishimura, M.; Chance, B. Determination of carotenes by thin-layer chromatography. Anal. Biochem. 1969, 29, 339–342. [Google Scholar] [CrossRef]
- Christensen, I.B.; Vedel, C.; Clausen, M.-L.; Kjærulff, S.; Agner, T.; Nielsen, D.S. Targeted screening of lactic acid bacteria with antibacterial activity toward Staphylococcus aureus clonal complex type 1 associated with atopic dermatitis. Front. Microbiol. 2021, 12, 733847. [Google Scholar] [CrossRef]
- Cavruc, V.; Chiricescu, A. Sarea, Timpul şi Omul; Editura: Angustia, Sfântu Gheorghe, Romania, 2006; Available online: https://www.academia.edu/5093178/Sarea_Timpul_si_Omul (accessed on 15 January 2025).
- Mnif, S.; Chamkha, M.; Sayadi, S. Isolation and characterization of Halomonas sp. strain C2SS100, a hydrocarbon-degrading bacterium under hypersaline conditions. J. Appl. Microbiol. 2009, 107, 785–794. [Google Scholar] [CrossRef]
- Cristea, A.; Baricz, A.; Leopold, N.; Floare, C.; Borodi, G.; Kacso, I.; Tripon, S.; Bulzu, P.; Andrei, A.Ș.; Cadar, O.; et al. Polyhydroxybutyrate production by an extremely halotolerant Halomonas elongata strain isolated from the hypersaline meromictic Fără Fund lake (Transylvanian Basin, Romania). J. Appl. Microbiol. 2018, 125, 1343–1357. [Google Scholar] [CrossRef]
- Kaye, J.Z.; Baross, J.A. High incidence of halotolerant bacteria in Pacific hydrothermal-vent and pelagic environments. FEMS Microbiol. Ecol. 2000, 32, 249–260. [Google Scholar] [CrossRef]
- Guevara-Luna, J.; Arroyo-Herrera, I.; Tapia-García, E.Y.; Estrada-de Los Santos, P.; Ortega-Nava, A.J.; Vásquez-Murrieta, M.S. Diversity and biotechnological potential of cultivable halophilic and halotolerant bacteria from the “Los Negritos” geothermal area. Microorganisms 2024, 12, 482. [Google Scholar] [CrossRef] [PubMed]
- Stackebrandt, E.; Ebers, J. Taxonomic parameters revisited: Tarnished gold standards. Microbiol. Today 2006, 33, 152–155. [Google Scholar]
- Hobmeier, K.; Cantone, M.; Nguyen, Q.A.; Pflüger-Grau, K.; Kremling, A.; Kunte, H.J.; Pfeiffer, F.; Marin-Sanguino, A. Adaptation to varying salinity in Halomonas elongata: Much more than ectoine accumulation. Front. Microbiol. 2022, 13, 846677. [Google Scholar] [CrossRef]
- Fariq, A.; Yasmin, A.; Jamil, M. Production, characterization and antimicrobial activities of bio-pigments by Aquisalibacillus elongatus MB592, Salinicoccus sesuvii MB597, and Halomonas aquamarina MB598 isolated from Khewra Salt Range, Pakistan. Extremophiles 2019, 23, 435–449. [Google Scholar] [CrossRef]
- Samrot, A.V.; Divya, R.; Narendrakumar, G.; Abirami, S.; Dhiva, S.; Prakash, P.; Jane Cypriyana, P.J.; Padmanaban, S. Bioprospecting studies of halophilic bacteria—Streptomyces sp. MA05 and Halobacterium sp. MA06. Lett. Appl. NanoBioSci. 2020, 9, 1583–1594. [Google Scholar]
- Hassan, A.H.A.; Alkhalifah, D.H.M.; Al Yousef, S.A.; Beemster, G.T.S.; Mousa, A.S.M.; Hozzein, W.N.; AbdElgawad, H. Salinity stress enhances the antioxidant capacity of Bacillus and Planococcus species isolated from a saline lake environment. Front. Microbiol. 2020, 11, 561816. [Google Scholar] [CrossRef]
- Saum, S.H.; Müller, V. Regulation of osmoadaptation in the moderate halophile Halobacillus halophilus: Chloride, glutamate and switching osmolyte strategies. Saline Syst. 2008, 4, 4. [Google Scholar] [CrossRef] [PubMed]
- Vargas, C.; Argandoña, M.; Reina-Bueno, M.; Rodríguez-Moya, J.; Fernández-Aunión, C.; Nieto, J.J. Unravelling the adaptation responses to osmotic and temperature stress in Chromohalobacter salexigens, a bacterium with broad salinity tolerance. Saline Syst. 2008, 4, 1–9. [Google Scholar] [CrossRef] [PubMed]
- Mukhtar, S.; Abdulla, M.K.; Samina, M. Osmoadaptation in halophilic bacteria and archaea. Res. J. Biotechnol. 2020, 15, 5. [Google Scholar]
- Yu, J.; Zhang, Y.; Liu, H.; Liu, Y.; Mohsin, A.; Liu, Z.; Zheng, Y.; Xing, J.; Han, J.; Zhuang, Y.; et al. Temporal dynamics of stress response in Halomonas elongata to NaCl shock: Physiological, metabolomic, and transcriptomic insights. Microb. Cell Fact. 2024, 23, 88. [Google Scholar] [CrossRef]
- Segura, A.; Hurtado, A.; Rivera, B.; Lăzăroaie, M.M. Isolation of new toluene-tolerant marine strains of bacteria and characterization of their solvent-tolerance properties. J. Appl. Microbiol. 2008, 104, 1408–1416. [Google Scholar] [CrossRef]
- Akbari, A.; David, C.; Rahim, A.A.; Ghoshal, S. Salt selected for hydrocarbon-degrading bacteria and enhanced hydrocarbon biodegradation in slurry bioreactors. Water Res. 2021, 202, 117424. [Google Scholar] [CrossRef]
- Sikkema, J.; de Bont, J.A.M.; Poolman, B. Mechanisms of membrane toxicity of hydrocarbons. Microbiol. Rev. 1995, 59, 201–222. [Google Scholar] [CrossRef] [PubMed]
- Sardessai, Y.N.; Bhosle, S. 2004 Industrial potential of organic solvent tolerant bacteria. Biotechnol. Prog. 2004, 20, 655–660. [Google Scholar] [CrossRef] [PubMed]
- Mainka, T.; Weirathmüller, D.; Herwig, C.; Pflügl, S. Potential applications of halophilic microorganisms for biological treatment of industrial process brines contaminated with aromatics. J. Ind. Microbiol. Biotechnol. 2021, 48, kuab015. [Google Scholar] [CrossRef]
- Kumar, S.; Karan, R.; Kapoor, S.; Singh, S.P.; Khare, S.K. Screening and isolation of halophilic bacteria producing industrially important enzymes. Braz. J. Microbiol. 2012, 43, 1595–1603. [Google Scholar] [CrossRef] [PubMed]
- Ruginescu, R.; Gomoiu, I.; Popescu, O.; Cojoc, R.; Neagu, S.; Lucaci, I.; Batrinescu-Moteau, C.; Enache, M. Bioprospecting for novel halophilic and halotolerant sources of hydrolytic enzymes in brackish, saline and hypersaline lakes of Romania. Microorganisms 2020, 8, 1903. [Google Scholar] [CrossRef]
- Le Borgne, S.; Paniagua, D.; Vazquez-Duhalt, R. Biodegradation of organic pollutants by halophilic bacteria and archaea. J. Mol. Microbiol. Biotechnol. 2008, 15, 74–92. [Google Scholar] [CrossRef]
- Fathepure, B.Z. Recent studies in microbial degradation of petroleum hydrocarbons in hypersaline environments. Front. Microbiol. 2014, 5, 173. [Google Scholar] [CrossRef]
- Drissi Kaitouni, L.B.; Anissi, J.; Sendide, K.; El Hassouni, M. Diversity of hydrolase-producing halophilic bacteria and evaluation of their enzymatic activities in submerged cultures. Ann. Microbiol. 2020, 70, 33. [Google Scholar] [CrossRef]
- Hashemzahi, A.; Makhkdoumi, A.; Asoodeh, A. Culturable diversity and enzyme production survey of halophilic prokaryotes from a solar saltern on the shore of the Oman Sea. J. Genet. Resour. 2020, 6, 1–11. [Google Scholar]
- Schultz, J.; Rosado, A.S. Extreme environments: A source of biosurfactants for biotechnological applications. Extremophiles 2020, 24, 189–206. [Google Scholar] [CrossRef] [PubMed]
- Neifar, M.; Chouchane, H.; Najjari, A.; El Hidri, D.; Mahjoubi, M.; Ghedira, K.; Naili, F.; Soufi, L.; Raddadi, N.; Sghaier, H.; et al. Genome analysis provides insights into crude oil degradation and biosurfactant production by extremely halotolerant Halomonas desertis G11 isolated from Chott El-Djerid salt-lake in the Tunisian desert. Genomics 2019, 111, 1802–1814. [Google Scholar] [CrossRef]
- Donio, M.B.; Ronica, F.A.; Viji, V.T.; Velmurugan, S.; Jenifer, J.S.; Michaelbabu, M.; Dhar, P.; Citarasu, T. Halomonas sp. BS4, a biosurfactant-producing halophilic bacterium isolated from solar salt works in India and its biomedical importance. SpringerPlus 2013, 2, 149. [Google Scholar] [CrossRef]
- Cameotra, S.S.; Makkar, R.S. Synthesis of biosurfactants in extreme conditions. Appl. Microbiol. Biotechnol. 1998, 50, 520–529. [Google Scholar] [CrossRef] [PubMed]
- Donio, M.B.; Ronica, S.F.; Viji, V.T.; Velmurugan, S.; Jenifer, J.A.; Michaelbabu, M.; Citarasu, T. Isolation and characterization of halophilic Bacillus sp. BS3 able to produce pharmacologically important biosurfactants. Asian Pac. J. Trop. Med. 2013, 6, 876–883. [Google Scholar] [CrossRef]
- Fariq, A.; Yasmin, A. Production, characterization and bioactivities of biosurfactants from newly isolated strictly halophilic bacteria. Process Biochem. 2020, 98, 1–10. [Google Scholar] [CrossRef]
- Waghmode, S.; Suryavanshi, M.; Sharma, D.; Satpute, S.K. Planococcus species—An imminent resource to explore biosurfactant and bioactive metabolites for industrial applications. Front. Bioeng. Biotechnol. 2020, 8, 996. [Google Scholar] [CrossRef]
- Corti Monzón, G.; Nisenbaum, M.; Herrera Seitz, M.K.; Murialdo, S.E. New findings on aromatic compounds’ degradation and their metabolic pathways, the biosurfactant production and motility of the halophilic bacterium Halomonas sp. KHS3. Curr. Microbiol. 2018, 75, 1108–1118. [Google Scholar] [CrossRef]
- Arino, S.; Marchal, R.; Vandecasteele, J.P. Identification and production of a rhamnolipidic biosurfactant by a Pseudomonas species. Appl. Environ. Microbiol. 1996, 45, 162–168. [Google Scholar] [CrossRef]
- George, S.; Jayachandran, K. Analysis of rhamnolipid biosurfactants produced through submerged fermentation using orange fruit peelings as sole carbon source. Appl. Biochem. Biotechnol. 2009, 158, 694–705. [Google Scholar] [CrossRef] [PubMed]
- Marzban, A.; Ebrahimipour, G.; Danesh, A. Bioactivity of a Novel Glycolipid Produced by a Halophilic Buttiauxella sp. and Improving Submerged Fermentation Using a Response Surface Method. Molecules 2016, 21, 1256. [Google Scholar] [CrossRef] [PubMed]

| Characteristics | Strain | |||
|---|---|---|---|---|
| SB8 | CN6 | CN8 | IB5 | |
| Isolation source | Băicoi soil | Curmătura mud | Curmătura mud | Băicoi water |
| Growth on: | ||||
| JCM168 agar | + | − | − | − |
| MH agar | + | + | + | + |
| Chloramphenicol (0.002%) | − | − | − | − |
| Sodium deoxycholate (0.004%) | + | + | + | + |
| Color of colonies | creamy | beige | orange | beige |
| Temperature growth (°C) | 37 | 30 | 30 | 30 |
| Gram | − | + | + | − |
| Cell shape | cocci | bacilli | coccobacilli | coccobacilli |
| Motility | − | − | + | + |
| Respiratory type | A, FA | A, FA | A, FA | A, FA |
| Catalase | − | + | + | − |
| Oxidase | + | + | + | + |
| Salt tolerance capacity (growth on/in MH-NaCl) | ||||
| MH-NaCl agar (CF) | 0–4 M | 0–2 M | 0–2 M | 1–3 M |
| MH-NaCl broth (GK) | 0–3 M | 0–2 M | 0–2 M | 0–3 M |
| MH-NaCl broth (CV) | 0–5 M | 0–2 M | 0–3 M | 0–5 M |
| PCR 16S rRNA gene using primers for | ||||
| Bacteria (1465 bp) | + | + | + | + |
| Archaea (1472 bp) | − | − | − | − |
| RAPD using primer: | ||||
| AP12 | + | + | − | + |
| AP5 | + | + | − | + |
| 16S rRNA gene sequence identity | Halomonas elongata | Bacillus altitudinis | Planococcus rifietoensis | Halomonas stenophila |
| Characteristics | Strain | |||
|---|---|---|---|---|
| SB8 | CN6 | CN8 | IB5 | |
| Hydrocarbons tolerance (growth on MH agar, CF) | ||||
| Control | + | + | + | + |
| Diesel | + | + | − | + |
| Kerosene | + | − | − | − |
| n-Hexane | + | + | + | − |
| n-Hexadecane | + | + | + | + |
| Hydrocarbons tolerance (growth in MH broth, GK, CV) | ||||
| Control | +, + | +, + | +, + | +, + |
| Diesel | +, + | +, + | −, + | +, + |
| Kerosene | +, + | −, + | −, + | −, − |
| n-Hexane | +, + | +, + | +, + | +, + |
| n-Hexadecane | +, + | −, + | −, + | +, + |
| Characteristics | Strain | |||
|---|---|---|---|---|
| SB8 | CN6 | CN8 | IB5 | |
| Extracellular hydrolase production: | ||||
| Lipase (Tween-80) | + | + | − | − |
| Protease (casein) | − | + | + | + |
| Amylase (starch) | + | − | − | − |
| Cellulase (carboxymethylcellulose) | − | + | + | + |
| Xylanase (xylan) | − | + | − | + |
| Pectinase (pectin) | − | − | − | − |
| Biosurfactants production | ||||
| Emulsification index (E24, %) | 100 | 100 | − | − |
| Methylene blue (OD625) | 1.94 | 1.50 | 1.42 | 1.76 |
| CTAB | − | − | − | − |
| HPTLC (Rf) | 0.39–0.72 | 0.38–0.71 | 0.38–0.72 | 0.37–0.72 |
| Antimicrobial activity | ||||
| E. coli ATCC25922 | + | + | + | + |
| P. aeruginosa ATCC 15442 | − | + | + | + |
| S. aureus ATCC25923 | − | − | − | − |
| C. albicans ATCC 10231 | − | − | + | + |
| Carotenoid pigments production | ||||
| Total concentration (μg/mL) | 64.96 | 15.76 | 453.44 | 162.80 |
| HPTLC (Rf) | 0.06–0.35 | 0.07–0.43 | 0.08–0.46 | 0.07–0.47 |
| Antimicrobial activity | ||||
| E. coli ATCC25922 | + | − | + | + |
| P. aeruginosa ATCC 15442 | + | − | − | + |
| S. aureus ATCC25923 | − | − | − | − |
| C. albicans ATCC 10231 | + | + | + | + |
Disclaimer/Publisher’s Note: The statements, opinions and data contained in all publications are solely those of the individual author(s) and contributor(s) and not of MDPI and/or the editor(s). MDPI and/or the editor(s) disclaim responsibility for any injury to people or property resulting from any ideas, methods, instructions or products referred to in the content. |
© 2025 by the authors. Licensee MDPI, Basel, Switzerland. This article is an open access article distributed under the terms and conditions of the Creative Commons Attribution (CC BY) license (https://creativecommons.org/licenses/by/4.0/).
Share and Cite
Neagu, S.; Stancu, M.M. Novel Halotolerant Bacteria from Saline Environments: Isolation and Biomolecule Production. BioTech 2025, 14, 49. https://doi.org/10.3390/biotech14020049
Neagu S, Stancu MM. Novel Halotolerant Bacteria from Saline Environments: Isolation and Biomolecule Production. BioTech. 2025; 14(2):49. https://doi.org/10.3390/biotech14020049
Chicago/Turabian StyleNeagu, Simona, and Mihaela Marilena Stancu. 2025. "Novel Halotolerant Bacteria from Saline Environments: Isolation and Biomolecule Production" BioTech 14, no. 2: 49. https://doi.org/10.3390/biotech14020049
APA StyleNeagu, S., & Stancu, M. M. (2025). Novel Halotolerant Bacteria from Saline Environments: Isolation and Biomolecule Production. BioTech, 14(2), 49. https://doi.org/10.3390/biotech14020049

